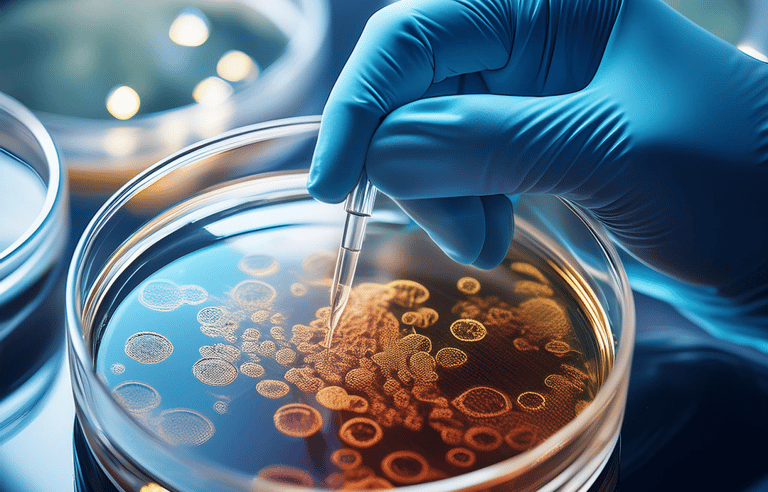
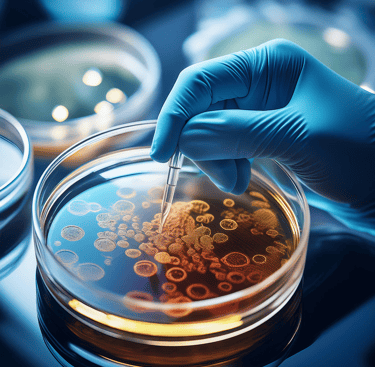

فحص زراعة البكتيريا : أفضل طريقة لاكتشاف البكتيريا في جسم الابل وعلاجها
تُعتبر الإبل من الحيوانات القيمة، ومعرضة للإصابة بالعديد من الأمراض البكتيرية. تُعد زراعة البكتيريا من عينة الدم والبول من أفضل الطرق لاكتشاف البكتيريا وتحديد العلاج المناسب لمقاومتها. في هذا المقال، سنستعرض أهمية هذه الطريقة وكيف تسهم في الحفاظ على صحة الهجن.

1. ما هو فحص زراعة البكتيريا؟
فحص زراعة البكتيريا هو تقنية مخبرية تُستخدم للكشف عن وجود البكتيريا في عينات الدم أو البول. يتم جمع العينات وزرعها في بيئات مناسبة تسمح للبكتيريا بالنمو، مما يساعد في تحديد نوع البكتيريا المسببة للعدوى. و بعد ذلك يتم تحديد المضادات الحيوية الفعالة و المناسبة و كذلك تحديد المضادات الحيوية الغير فعالة.
2. أهمية فحص زراعة البكتيريا
- تحديد نوع البكتيريا : تحديد نوع البكتيريا المسببة للعدوى يمكّن الأطباء البيطريين من كيفية التعامل مع الحالة.
- تقييم فعالية العلاج: يمكن استخدام هذا الفحص في اختيار المضادات الحيوية المناسبة و الفعالة. مما يعتبر مهما لتجنب استخدام المضادات الحيوية الغير مناسبة.
3. كيفية إجراء فحص زراعة البكتيريا
3.1. جمع العينات : تُجمع عينات الدم أو البول باستخدام أدوات معقمة و من قبل اطباء بيطرين مختصين.
3.2. زراعة العينة: تُزرع العينة في بيئات خاصة في المختبر.
3.3. المراقبة: تُراقب العينة لمدة عدة أيام بحثًا عن نمو البكتيريا في حال ظهورها.
3.4. اختبار الحساسية المضاد الحيوي: بعد تحديد نوع البكتيريا، يتم إجراء اختبار حساسية لتحديد المضاد الحيوي الأنسب، مما يساعد في:
- اختيار العلاج الصحيح : ضمان استخدام المضاد الحيوي الأكثر فعالية.
- تجنب المقاومة: تقليل خطر تطور مقاومة البكتيريا للمضادات الحيوية.
فحص زراعة البكتيريا هو الطريقة المثلى لاكتشاف البكتيريا في جسم الابل و علاجها. يسهم في تحديد نوع عن العدوى وتحديد العلاج المناسب، مما يساعد في الحفاظ على صحة الابل وأدائها. يُنصح المربون بإجراء هذا الفحص بشكل دوري لضمان سلامة قطيعهم.
الكلمات المفتاحية: هجن - إبل - فحص الزراعة - بكتيريا
